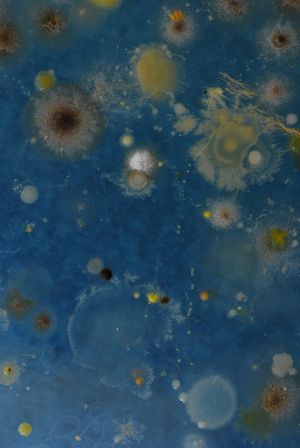

Luciana Paoletti es artista plástica, biotecnóloga y Doctora en Ciencia Biológicas. De allí que su obra se caracterice por vincular el arte con la biología. Paoletti se obsesiona con hacer visible lo invisible. Acostumbrada a trabajar en el ámbito del laboratorio, su desafío es desnaturalizar su práctica profesional para poder producir obras de arte que la deslumbren como espectadora, como artista y como científica. Es por ello que intenta diferenciarse de aquellos bioartistas o grupos de bioarte que se limitan a mostrar en el museo el espacio de producción científica (el laboratorio), por ejemplo, o simples imágenes de virus, bacterias u otro tipo de microorganismos que crecen a partir de un cultivo creado en el marco de un proceso de rutina.
En conversación con Ludión, Paoletti describe sus Bio-pinturas como un proyecto donde “la pintura es reemplazada por microorganismos (principalmente bacterias y hongos). Inicialmente aíslo los microorganismos de diferentes fuentes, los selecciono por sus características de crecimiento y reproduzco hasta obtener las cantidades necesarias de cada uno de ellos. Estudio el crecimiento en forma individual y conjunta que me permitirá realizar los bocetos (protocolos) para cada dibujo. Posteriormente dibujo con los microorganismos sobre placas conteniendo medios de cultivo (…).Cuando las bacterias y hongos crecen aparece la imagen que finalmente es fotografiada (ya que los microorganismos mueren al consumirse los nutrientes)”.
Para un espectador desprevenido, su estudio/taller artístico puede resultar particular dado que consiste, principalmente, en una mesa de trabajo donde encontramos: un mechero, placas con medio de cultivo rico y sólido, probetas, una importante cámara fotográfica y un artefacto –donde se depositan los platos de Petri para ser fotografiados– que irradia luz desde abajo permitiendo que se ilumine la placa para capturar la imagen del cultivo que la artista produjo. Dentro de sus principales series podemos citar los proyectos Bio-pinturas, Momentos Invisibles, Retratos y Momentos Impresionistas.
En Retratos y Momentos Invisibles, la artista retoma lo que uno de sus maestros del taller El Levante, Mauro Machado, presentó por primera vez a finales de la década del noventa en la escena rosarina. Paoletti realiza un aislamiento de bacterias y hongos del cuerpo de la persona retratada o captura los microorganismos presentes, por ejemplo, en su fiesta de cumpleaños (invitados invisibles), tal como Machado dejaba que la atmósfera del Café de la Ópera de Rosario se plasmara en sus discos de Petri que apoyaba sobre la mesa del bar mientras creaba Conversando en el Café de la Ópera (1999).
El proyecto más ambicioso de Paoletti es Momentos Impresionistas, para el que sale con su bolso de herramientas en busca de paisajes. Una vez elegida la situación que quiere registrar, se detiene y toma impresiones invisibles (captura de microorganismos), que serán únicas y características, porque dependen del lugar, la hora y el tiempo que allí permanezca. “Establezco una relación similar a la de los artistas impresionistas con sus obras, ya que analizo estos momentos y los capturo con un método propio para producir imágenes que los registren”. La principal diferencia entre este proyecto y los mencionados anteriormente es que los hongos y las bacterias que aísla con posterioridad a su captura, crecen al punto de que pueden ser observados macroscópicamente, es decir, a simple vista. Durante el lapso que dura el despliegue tridimensionalidad de ese paisaje “in vitro”, Paoletti realiza las fotografías que, en muchos casos, sorprenden por su parecido con paisajes existentes en la naturaleza como desiertos o glaciares.
Finalmente, la artista explica: “Utilizo un método que me permite, de una manera particular, ‘acariciar un paisaje’ para luego analizar los microorganismos que se han depositado en mis manos”. Una vez que los microorganismos consumen todos los nutrientes que la placa les proporciona, mueren recordándonos lo efímero de la vida y del arte que producen.
http://www.visible-in-visible.blogspot.com.ar/
Lebenglik, Fabián. “El arte es un virus” en Página 12, 26/10/99, disponible en: http://www.pagina12.com.ar/1999/99-10/99-10-26/pag31.htm, consultado al 28/08/2012.